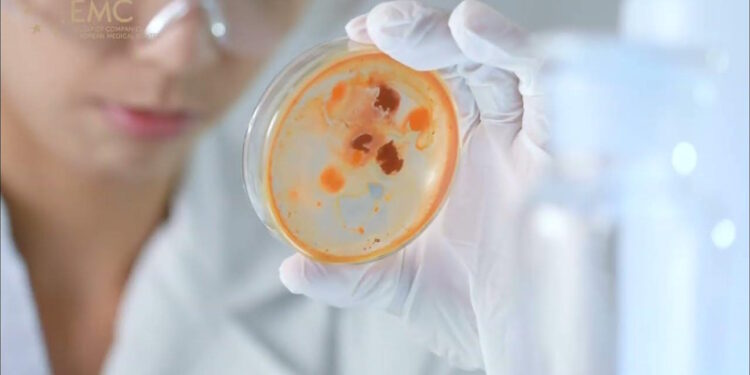
Карциноїдні пухлини кишківника

Карциноїдні пухлини, або нейроендокринні пухлини (НЕП) кишківника, є рідкісними новоутвореннями, що виникають з нейроендокринних клітин травного тракту. За останні три десятиліття частота їх виявлення значно зросла завдяки вдосконаленню діагностичних методів. Щорічно реєструється 40–50 випадків на мільйон населення, при цьому близько 60% усіх НЕП локалізуються в тонкому кишечнику.
Розгляньмо найпоширеніші запитання, щоб краще зрозуміти ці новоутворення та їхні прояви.
1. Що таке карциноїдні пухлини кишківника?
Карциноїдні пухлини — це різновид нейроендокринних пухлин, які походять з клітин ендокринної системи, що розсіяні по всьому травному тракту. Ці клітини відповідають за вироблення гормонів, і коли вони перетворюються на пухлину, можуть надмірно секретувати біологічно активні речовини, такі як серотонін, гістамін, брадикінін тощо.
2. Які основні типи карциноїдних пухлин існують за локалізацією?
Залежно від місця розташування, карциноїдні пухлини поділяють на три основні типи:
- Пухлини передньої кишки: включають стравохід, шлунок, дванадцятипалу кишку.
- Пухлини середньої кишки: охоплюють тонку кишку, сліпу кишку, висхідну ободову кишку. Саме цей тип найчастіше викликає карциноїдний синдром через інтенсивну секрецію серотоніну та інших біологічно активних речовин.
- Пухлини задньої кишки: локалізуються в низхідній ободовій кишці, сигмоподібній кишці, прямій кишці.
3. Чому карциноїдні пухлини важко діагностувати?
Діагностика карциноїдних пухлин є складним завданням з кількох причин:
Безсимптомний перебіг: Менше 10% пацієнтів мають симптоми на момент діагностики. Пухлини ростуть повільно, часто безсимптомно протягом років.
Середній вік: Середній вік встановлення діагнозу становить 55–65 років.
Неспецифічність симптомів: Симптоми часто схожі на інші, більш поширені захворювання травної системи, що призводить до затримки діагностики.
4. Які симптоми характерні для карциноїдного синдрому?
Карциноїдний синдром розвивається лише у 10–30% пацієнтів і є наслідком надмірної секреції гормонів. Він проявляється чотирма основними компонентами:
Почервоніння шкіри (флашинг):
- Спостерігається у 85–90% пацієнтів із синдромом.
- Епізоди тривають від кількох хвилин до кількох годин.
- Супроводжуються відчуттям жару в обличчі та верхній частині тулуба.
- Можуть провокуватися алкоголем, стресом, фізичним навантаженням або прийомом їжі.
Діарея:
- Виникає у 70–80% випадків.
- Носить водянистий характер, може бути профузною — до 10–30 разів на добу.
- Часто супроводжується абдомінальними спазмами та може призводити до значного зневоднення.
Бронхоспазм:
- Розвивається у 10–20% пацієнтів.
- Проявляється свистячим диханням, задишкою, може нагадувати напади бронхіальної астми.
- Особливо небезпечним є розвиток карциноїдної кризи з тяжким бронхоспазмом.
Ураження серця:
- Спостерігається у 50–60% пацієнтів з довготривалим карциноїдним синдромом.
- Розвивається фіброз тристулкового та легеневого клапанів, що може призвести до серцевої недостатності.
5. Які симптоми вказують на локальний ріст пухлини?
Залежно від розміру та локалізації, карциноїдні пухлини можуть викликати місцеві симптоми:
Абдомінальний біль: Розвивається у 35–40% випадків, може бути постійним або спастичним. При пухлинах тонкої кишки біль часто локалізується навколо пупка або в правій здухвинній ділянці.
Кишкова непрохідність: Може виникати при великих пухлинах або метастатичному ураженні брижі. Часткова непрохідність проявляється періодичними болями, здуттям живота, закрепами.
Кровотеча з пухлини: Зустрічається рідше порівняно з іншими типами кишкових новоутворень, але може призводити до хронічної анемії.
6. Як локалізація пухлини впливає на симптоми?
Локалізація пухлини | Типові прояви |
Шлунок | Рідко викликають карциноїдний синдром; частіше проявляються диспептичними розладами, схожими на виразкову хворобу. |
Тонка кишка | Найчастіше асоціюються з карциноїдним синдромом, особливо за наявності печінкових метастазів. Можуть викликати інтермітуючу кишкову непрохідність. |
Товста кишка | Рідко секретують серотонін у значних кількостях; частіше проявляються змінами характеру дефекації, ректальною кровотечею. |
7. Коли слід запідозрити карциноїдну пухлину?
Підозра на карциноїдну пухлину повинна виникати при поєднанні наступних симптомів, особливо якщо вони є стійкими або не піддаються стандартному лікуванню:
- Повторні епізоди почервоніння обличчя невідомої етіології.
- Хронічна діарея, що не піддається стандартному лікуванню.
- Абдомінальний біль у поєднанні з флашингом.
- Бронхоспазм, що виникає одночасно зі шкірними проявами.
- Прогресуюча серцева недостатність з ураженням правих відділів серця.
8. Які методи діагностики є найбільш інформативними?
Для діагностики карциноїдних пухлин застосовують комплексний підхід:
Біохімічна діагностика:
- Визначення рівня серотоніну в крові.
- Визначення 5-гідроксіндолоцтової кислоти (5-ГІОК) у добовій сечі. Підвищення цих показників у 2–3 рази свідчить про наявність функціонуючої карциноїдної пухлини.
Хромогранін А (ХрА): Є універсальним маркером нейроендокринних пухлин, підвищується у 80–90% випадків карциноїдів, незалежно від наявності синдрому.
Візуалізаційна діагностика:
- Комп’ютерна томографія (КТ) з контрастуванням.
- Магнітно-резонансна томографія (МРТ).
- Ендоскопічні методи.
- Сцинтиграфія з октреотидом (ОктреоСкан): Особливо цінна, оскільки дозволяє виявити первинну пухлину та метастази за рахунок зв’язування з соматостатиновими рецепторами на клітинах пухлини.
9. Чи можна вилікувати карциноїдні пухлини?
Прогноз залежить від стадії захворювання на момент діагностики. При локалізованих пухлинах 5-річна виживаність становить 85–95%.
- Хірургічне видалення: Є методом вибору для локалізованих пухлин.
- При метастатичних формах: Застосовуються аналоги соматостатину, таргетна терапія, радіонуклідна терапія.
Рання діагностика карциноїдних пухлин є критично важливою, оскільки своєчасне лікування може запобігти розвитку карциноїдного синдрому та значно покращити прогноз пацієнта.
Пам’ятайте, що будь-які незрозумілі або стійкі симптоми, особливо ті, що згадуються вище, повинні стати приводом для негайного звернення до лікаря. Ваше здоров’я у ваших руках!